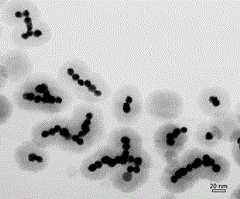
Figure 201210023975

技术领域technical field
本发明涉及一种具有可调拉曼散射效应的探针及其制备技术,尤其是一种由贵金属纳米颗粒组装成链状结构、其表面包覆有溶胶凝胶SiO2层、并在SiO2层表面修饰有不同官能团的增强拉曼散射探针及其制备方法。The invention relates to a probe with adjustable Raman scattering effect and its preparation technology, especially a chain structure assembled from noble metal nanoparticles, the surface of which is coated with a sol-gel SiO2 layer, and the SiO2 Enhanced Raman scattering probe with layer surface modified with different functional groups and preparation method thereof.
背景技术Background technique
表面等离子体共振(surface plasmon resonance,SPR)性质是金属纳米晶所独具的光学性质,是近年来的国际研究热点之一,而表面增强拉曼散射(Surface Enhanced Raman Scattering,SERS)光谱则正是基于金属表面等离子体共振的最主要的应用之一。表面增强拉曼散射是指当一些分子被吸附到某些粗糙的金属(如银、铜、金等) 表面上时,它们的拉曼散射强度会增加104~106倍。由于SERS具有很高的灵敏度,能够检测到吸附在金属表面的单分子层和亚单分子层的分子, 又能给出表面分子的结构信息, 被认为是一种很好的表面研究技术。Surface plasmon resonance (SPR) is a unique optical property of metal nanocrystals, and it is one of the international research hotspots in recent years, while Surface Enhanced Raman Scattering (SERS) spectroscopy is positive It is one of the most important applications based on metal surface plasmon resonance. Surface-enhanced Raman scattering means that when some molecules are adsorbed on the surface of some rough metals (such as silver, copper, gold, etc.), their Raman scattering intensity will increase by 104 to 106 times. Due to its high sensitivity, SERS can detect the monomolecular layer and submonolayer molecules adsorbed on the metal surface, and can give the structure information of the surface molecules, so it is considered as a good surface research technique.
大量研究表明贵金属纳米晶大多具有很强的表面拉曼散射增强效应,且研究发现, 不同种类的贵金属纳米晶有其独特的表面等离子体吸收带,比如银纳米颗粒典型的吸收带位于370-430 nm,金纳米颗粒典型的吸收带则位于520 nm左右。除此之外,贵金属纳米晶的大小和形貌也对其表面拉曼散射增强效应产生直接影响。而基于这些纳米颗粒的自组装,则可以产生不同的链状结构,由此引起其表面等离子体吸收带峰位的变化,当入射光波长与等离子体吸收带峰位匹配时,则可以产生明显的拉曼增强效应,从而使得自组装后的纳米颗粒在拉曼检测方面显示出重要应用。自组装通常发生在溶液条件下,是一种不稳定的状态(容易解体),如欲对这些自组装进行实际应用,则必须将这些自组装的结构进行固定。溶胶凝胶SiO2是一种非常有用的材料,一方面溶胶凝胶化学使得贵金属纳米颗粒的自组装和SiO2包覆变得容易操作,另一方面,SiO2是一种很好的壳材料,自身有很好的生物适应性和稳定性,表面很容易功能化(表面修饰官能团分子后,易与待测物种键合,从而增强拉曼散射效应),而且由于SiO2层对拉曼信号没有任何吸收,其对于贵金属纳米颗粒的增强拉曼散射效应没有任何不良影响,因此用溶胶凝胶SiO2壳包覆自组装后的贵金属纳米颗粒,并在SiO2壳表面修饰不同官能团分子,这些官能团很容易的和拉曼分子结合,进而得到具有可调拉曼散射增强效应的探针,所得探针将会在探针领域具有重要应用。A large number of studies have shown that most noble metal nanocrystals have a strong surface Raman scattering enhancement effect, and studies have found that different types of noble metal nanocrystals have their unique surface plasmon absorption bands. For example, the typical absorption band of silver nanoparticles is located at 370-430 nm, and the typical absorption band of gold nanoparticles is around 520 nm. In addition, the size and shape of noble metal nanocrystals also have a direct impact on their surface Raman scattering enhancement effect. Based on the self-assembly of these nanoparticles, different chain structures can be produced, which can cause changes in the peak position of the surface plasmon absorption band. When the wavelength of the incident light matches the peak position of the plasmon absorption band, a significant The Raman enhancement effect makes the self-assembled nanoparticles show important applications in Raman detection. Self-assembly usually occurs under solution conditions, which is an unstable state (easy to disassemble). If these self-assemblies are to be practically applied, these self-assembled structures must be fixed. Sol-gelSiO2 is a very useful material. On the one hand, sol-gel chemistry makes the self-assembly andSiO2 coating of noble metal nanoparticles easy to operate. On the other hand,SiO2 is a good shell material. , which has good biological adaptability and stability, and the surface is easy to functionalize (after the surface is modified with functional group molecules, it is easy to bond with the species to be measured, thereby enhancing the Raman scattering effect), and because the SiO2 layer has a strong influence on the Raman signal Without any absorption, it has no adverse effect on the enhanced Raman scattering effect of noble metal nanoparticles. Therefore, the self-assembled noble metal nanoparticles are coated with sol-gel SiO2 shells, and different functional group molecules are modified on the surface of SiO2 shells. These The functional groups are easily combined with Raman molecules to obtain probes with adjustable Raman scattering enhancement effect, and the obtained probes will have important applications in the field of probes.
发明内容Contents of the invention
本发明的目的在于提供一种具有可调拉曼散射效应的探针,该探针含有贵金属纳米颗粒组装而成的链状结构,形成的探针的吸收带可以随探针的长度及直径而发生移动,使探针在拉曼检测方面应用范围更广。The purpose of the present invention is to provide a probe with adjustable Raman scattering effect, the probe contains a chain structure assembled by noble metal nanoparticles, and the absorption band of the formed probe can vary with the length and diameter of the probe. The movement occurs, so that the probe can be used in a wider range of Raman detection.
本发明还提供了探针制备方法,该方法便于操作,采用自组装技术使纳米颗粒形成链状结构,并在其表面包覆上溶胶凝胶SiO2层,表面改性在溶胶凝胶反应中进行,所得产品更加具有实用性。The present invention also provides a probe preparation method, which is easy to operate, adopts self-assembly technology to make nanoparticles form a chain structure, and coats a sol-gelSiO layer on its surface, and the surface modification is performed in the sol-gel reaction. Carried out, the resulting product is more practical.
本发明是通过以下措施来实现的:The present invention is achieved through the following measures:
一种具有可调拉曼散射效应的探针,该探针以贵金属纳米颗粒自组装形成的纳米链为核,核上包覆有一层二氧化硅外壳,二氧化硅外壳上连接有拉曼探针分子。具体的,二氧化硅外壳通过修饰与其表面的官能团与拉曼探针分子连接,所述官能团为羟基、氨基、巯基、羧基或聚乙(烯)二醇基,所述官能团可以直接与拉曼分子共价及非共价连接。A probe with adjustable Raman scattering effect. The probe uses a nanochain formed by the self-assembly of noble metal nanoparticles as the core, and the core is covered with a layer of silica shell, and a Raman probe is connected to the silica shell. needle molecule. Specifically, the silica shell is connected to the Raman probe molecule by modifying the functional group on its surface, and the functional group is hydroxyl, amino, mercapto, carboxyl or polyethylene (ethylene) glycol, and the functional group can be directly connected to the Raman probe. Molecules are covalently and non-covalently linked.
上述探针中,贵金属纳米颗粒为Au、Ag、Pt、Pd,或者是Au、 Ag、Pt、 Pd形成的合金,或者是Au、 Ag、Pt、 Pd形成的核壳结构,贵金属纳米颗粒粒径在1-25nm;Among the above probes, the noble metal nanoparticles are Au, Ag, Pt, Pd, or an alloy formed by Au, Ag, Pt, Pd, or a core-shell structure formed by Au, Ag, Pt, Pd, and the particle size of the noble metal nanoparticles is at 1-25nm;
上述探针中,二氧化硅外壳的厚度为0.5-20nm;贵金属纳米链与二氧化硅的摩尔比为0.2-40:30-70。 In the above probes, the thickness of the silicon dioxide shell is 0.5-20 nm; the molar ratio of the noble metal nano chains to the silicon dioxide is 0.2-40:30-70. the
本发明所得探针的长度为3nm-10um,直径为3-40nm。探针中除含有贵金属纳米颗粒及SiO2,还含有H、S、C、O、Na、B等成份,这些成分是是加入的各种化学试剂引入的,这些化学成分的摩尔比为SiO2:金属纳米颗粒:C:H:O:N:S:Na:B为(30-70):(0.2-40):(0.1-1):(0.05-3):(0.1-3):(0-3):(0-1):(0-1):(0-1)。The probe obtained in the present invention has a length of 3nm-10um and a diameter of 3-40nm. In addition to noble metal nanoparticles and SiO2 , the probe also contains H, S, C, O, Na, B and other components. These components are introduced by adding various chemical reagents. The molar ratio of these chemical components is SiO2 : metal nanoparticles: C: H: O: N: S: Na: B for (30-70): (0.2-40): (0.1-1): (0.05-3): (0.1-3): ( 0-3):(0-1):(0-1):(0-1).
本发明还提供了本具有可调拉曼散射效应的探针的制备方法,通过本发明的方法所得的探针显示出贵金属纳米晶增强拉曼散射的性质,由于这些由贵金属纳米颗粒组成的链状结构所具有的特殊性能,本发明所述的材料在医药、生物领域将会产生很高的应用价值。此外,这些探针还可以被用于催化技术及用作电导材料。The present invention also provides the preparation method of the probe with tunable Raman scattering effect, the probe obtained by the method of the present invention shows the properties of noble metal nanocrystal enhanced Raman scattering, because these chains composed of noble metal nanoparticles Due to the special properties of the shape structure, the material of the present invention will have high application value in the fields of medicine and biology. In addition, these probes can also be used in catalytic technology and as electrically conductive materials.
本方法采用下述(1)、(3)、(5)、(6)步骤制备探针或者采用下述(2)、(4)、(5)、(6)步骤制备探针,其中步骤(1)、(3)、(5)、(6)的方法是在包覆SiO2壳前完成贵金属纳米颗粒的自组装,而步骤(2)、(4)、(5)、(6)的方法是在包覆SiO2壳的过程中完成贵金属纳米颗粒的自组装,具体步骤如下:This method uses the following steps (1), (3), (5) and (6) to prepare probes or uses the following steps (2), (4), (5) and (6) to prepare probes, wherein the steps The methods of (1), (3), (5), and (6) are to complete the self-assembly of noble metal nanoparticles before coating theSiO2 shell, while the steps (2), (4), (5), (6) The method is to complete the self-assembly of noble metal nanoparticles in the process of coating theSiO2 shell, and the specific steps are as follows:
一、贵金属纳米颗粒的自组装1. Self-assembly of noble metal nanoparticles
(1)、取贵金属纳米颗粒水溶液,加入用于自组装的极性分子试剂,搅拌反应,完成自组装;(1) Take the aqueous solution of noble metal nanoparticles, add polar molecular reagents for self-assembly, stir and react, and complete the self-assembly;
(2)、取贵金属纳米颗粒水溶液,加入醇、不含官能团的硅烷试剂和氨水,搅拌反应,完成自组装;(2) Take the aqueous solution of noble metal nanoparticles, add alcohol, silane reagent without functional groups and ammonia water, stir and react to complete the self-assembly;
二、SiO2壳层的包覆2. Coating of SiO2 shell
(3)、向步骤(1)中自组装后的溶液中加入醇,然后再加入不含官能团的硅烷试剂和氨水,搅拌反应,完成二氧化硅层的包覆,离心分离、洗涤得贵金属/二氧化硅复合颗粒;(3) Add alcohol to the self-assembled solution in step (1), then add silane reagent and ammonia water without functional groups, stir and react, complete the coating of the silica layer, centrifuge and wash to obtain precious metal/ Silica composite particles;
(4)、向步骤(2)中自组装所得的溶液中加入不含官能团的硅烷试剂和氨水,搅拌反应,完成二氧化硅层的包覆,离心分离、洗涤得贵金属/二氧化硅复合颗粒;(4) Add silane reagents and ammonia water without functional groups to the solution obtained from self-assembly in step (2), stir and react, complete the coating of the silica layer, centrifuge and wash to obtain noble metal/silica composite particles ;
三、贵金属/二氧化硅复合颗粒的表面官能团修饰3. Surface functional group modification of noble metal/silica composite particles
(5)、将制得的贵金属/二氧化硅复合颗粒分散于水和醇的溶液中,加入含有官能团的硅烷试剂,搅拌反应进行二氧化硅壳层的表面修饰,离心分离后,得到表面官能团修饰的贵金属/二氧化硅复合颗粒。(5) Disperse the prepared noble metal/silica composite particles in a solution of water and alcohol, add a silane reagent containing functional groups, stir and react to modify the surface of the silica shell, and obtain surface functional groups after centrifugation Modified noble metal/silica composite particles.
四、具有可调拉曼散射效应的探针的制备4. Preparation of probes with tunable Raman scattering effect
(6)、将制得的表面修饰有各种官能团的贵金属/二氧化硅复合颗粒分散于水或醇中,加入拉曼探针分子,搅拌反应后,离心分离,得到具有可调拉曼散射效应的探针。(6) Disperse the prepared noble metal/silica composite particles with various functional groups on the surface in water or alcohol, add Raman probe molecules, stir and react, and then centrifuge to obtain adjustable Raman scattering effect probes.
上述制备方法中,在实际操作中,首先要通过已经掌握的水溶液法合成一系列的贵金属纳米晶(详见文献Langmuir,2004,20,1909-1904;Langmuir,2008,24,5562-5568;J. Phys. Chem. C, 2007, 111, 17158-17162;Langmuir, 2002, 18, 3318-3318;J. Phys. Chem. C, 2007, 111, 5909-5914。),然后将这些贵金属纳米颗粒用化学手段组装成一维材料,之后在自组装后的一维材料上包覆溶胶凝胶SiO2层,并在SiO2层表面修饰不同官能团分子。In the above preparation method, in actual operation, a series of noble metal nanocrystals should first be synthesized by the already mastered aqueous solution method (see literature Langmuir, 2004, 20, 1909-1904; Langmuir, 2008, 24, 5562-5568; J . Phys. Chem. C, 2007, 111, 17158-17162; Langmuir, 2002, 18, 3318-3318; J. Phys. Chem. C, 2007, 111, 5909-5914.), and then these noble metal nanoparticles were used A one-dimensional material is assembled by chemical means, and then a sol-gelSiO2 layer is coated on the self-assembled one-dimensional material, and different functional group molecules are modified on the surface of theSiO2 layer.
上述步骤(1)中,贵金属纳米颗粒与极性分子的摩尔比为1.64×10-6~3.29×10-5:1,搅拌反应3-48小时。In the above step (1), the molar ratio of noble metal nanoparticles to polar molecules is 1.64×10-6 to 3.29×10-5 :1, and the reaction is stirred for 3-48 hours.
上述步骤(2)中,贵金属纳米颗粒和不含官能团的硅烷试剂的摩尔比为1: 1×102~2×103,不含官能团的硅烷试剂:H2O:醇:氨水的摩尔比为2×10-9~2×10-2:1:0.5~5:0.1~1,搅拌反应1-8h。In the above step (2), the molar ratio of noble metal nanoparticles to silane reagents without functional groups is 1: 1×102 to 2×103 , and the molar ratio of silane reagents without functional groups: H2 O : alcohol: ammonia water 2×10-9 ~ 2×10-2 : 1: 0.5 ~ 5: 0.1 ~ 1, stirring for 1-8 hours.
上述步骤(3)中,加入的不含官能团的硅烷试剂与贵金属纳米颗粒的摩尔比为1×102~7×105:1 ,不含官能团的硅烷:H2O:醇:氨水的摩尔比为2×10-9~4×10-3:1:0.5~5:0.1~1,搅拌反应1-10h。In the above step (3), the molar ratio of the added silane reagent without functional group to the noble metal nanoparticles is 1×102 to 7×105 : 1, and the molar ratio of silane without functional group: H2 O: alcohol: ammonia water The ratio is 2×10-9 ~ 4×10-3 : 1: 0.5 ~ 5: 0.1 ~ 1, and the reaction is stirred for 1-10 hours.
上述步骤(4)中,加入的不含官能团的硅烷试剂与贵金属纳米颗粒的摩尔比为1×103~1×108:1,不含官能团的硅烷:H2O:醇:氨水的摩尔比为2×10-9~4×10-3:1:0.5~5:0.1~1,搅拌反应1-10h。In the above step (4), the molar ratio of the added silane reagent without functional group to the noble metal nanoparticles is 1×103 to 1×108 : 1, and the molar ratio of silane without functional group: H2 O: alcohol: ammonia water The ratio is 2×10-9 ~ 4×10-3 : 1: 0.5 ~ 5: 0.1 ~ 1, and the reaction is stirred for 1-10 hours.
步骤(5)中,加入的含有官能团的硅烷试剂与贵金属纳米颗粒的摩尔比为1:1×102~7×105,含有官能团的硅烷:H2O:醇的摩尔比为2×10-9~4×10-3:1:0.5~5,搅拌反应3-48h。In step (5), the molar ratio of the added silane reagent containing functional groups to the noble metal nanoparticles is 1:1×102 to 7×105 , and the molar ratio of silane containing functional groups:H2 O:alcohol is 2×10-9 ~ 4×10-3 : 1: 0.5 ~ 5, stirring and reacting for 3-48h.
上述步骤(6)中,搅拌反应3-15h。In the above step (6), the reaction is stirred for 3-15 hours.
除氨水外,其他试剂均为纯的化学试剂。Except for ammonia water, other reagents are pure chemical reagents.
上述制备方法中,所述极性分子试剂为甲醇、乙醇、丙醇、丁醇、异丙醇、乙二胺、硼氢化钠、巯基乙酸、巯基丙酸、乙醇胺、二乙醇胺或三乙醇胺。In the above preparation method, the polar molecular reagent is methanol, ethanol, propanol, butanol, isopropanol, ethylenediamine, sodium borohydride, mercaptoacetic acid, mercaptopropionic acid, ethanolamine, diethanolamine or triethanolamine.
上述制备方法中,所述醇为甲醇、乙醇或丙醇;所述不含官能团的硅烷试剂为正硅酸甲酯、正硅酸乙酯、正硅酸丙酯、正硅酸丁酯、硅酸钠或偏硅酸钠。In the above preparation method, the alcohol is methanol, ethanol or propanol; the silane reagent without functional group is methyl orthosilicate, ethyl orthosilicate, propyl orthosilicate, butyl orthosilicate, silicon sodium bicarbonate or sodium metasilicate.
上述制备方法中,所述含有官能团的烷氧基硅烷试剂为含氨基的烷氧基硅烷试剂、含巯基的烷氧基硅烷试剂、含羧基的硅烷试剂或含PEG(聚乙(烯)二醇基)基的硅烷试剂;其中, 含氨基的烷氧基硅烷试剂为氨丙基三甲氧基硅烷、氨乙基三甲氧基硅烷、氨甲基三甲氧基硅烷、氨丙基三乙氧基硅烷、氨乙基三乙氧基硅烷、氨甲基三乙氧基硅烷、氨甲基三丙氧基硅烷、氨乙基三丙氧基硅烷、氨丙基三丙氧基硅烷;含巯基的烷氧基硅烷试剂为巯丙基三甲氧基硅烷、巯乙基三甲氧基硅烷、巯甲基三甲氧基硅烷、巯丙基三乙氧基硅烷、巯乙基三乙氧基硅烷、巯甲基三乙氧基硅烷、巯甲基三丙氧基硅烷、巯乙基三丙氧基硅烷、巯丙基三丙氧基硅烷;含羧基的硅烷试剂为羧乙基硅三醇钠盐或2-(carboxymethylthio)ethyltrimethylsilane;含PEG基硅烷试剂为2-[methoxy(polyethyleneoxy)propyl]-trimethoxy-silane、2-[methoxy(polyethyleneoxy)propyl]heptamethyltrisiloxane或2-[methoxy(polyethyleneoxy)propyl]-trichlorosilane。上述羧乙基硅三醇钠盐,英文命名为carboxyethylsilanetriol sodium ;2-(carboxymethylthio)ethyltrimethylsilane,化学式为C7H16O2SSi;2-[methoxy(polyethyleneoxy)propyl]-trimethoxy-silane,中文命名为2-[甲氧基(聚乙烯氧代)丙基]三甲氧基硅烷;2-[methoxy(polyethyleneoxy)propyl]heptamethyltrisiloxane,中文命名2-甲基-3-羟丙基甲基(硅氧烷与聚硅氧烷);2-[methoxy(polyethyleneoxy)propyl]-trichlorosilane,化学式CH3O(C2H4O)6-9C3H6Cl3Si,这些试剂可在市场上买到,厂商可选美国的Gelest Inc.公司。In the above preparation method, the alkoxysilane reagent containing the functional group is an amino-containing alkoxysilane reagent, a mercapto-containing alkoxysilane reagent, a carboxyl-containing silane reagent or a PEG (polyethylene (ethylene) glycol-containing base)-based silane reagents; wherein, amino-containing alkoxysilane reagents are aminopropyltrimethoxysilane, aminoethyltrimethoxysilane, aminomethyltrimethoxysilane, aminopropyltriethoxysilane , Aminoethyltriethoxysilane, Aminomethyltriethoxysilane, Aminomethyltripropoxysilane, Aminoethyltripropoxysilane, Aminopropyltripropoxysilane; Mercapto-containing alkanes Oxysilane reagents are mercaptopropyltrimethoxysilane, mercaptoethyltrimethoxysilane, mercaptomethyltrimethoxysilane, mercaptopropyltriethoxysilane, mercaptoethyltriethoxysilane, mercaptomethyl Triethoxysilane, mercaptomethyl tripropropoxy silane, mercaptoethyl tripropropoxy silane, mercaptopropyl tripropropoxy silane; carboxyl-containing silane reagents are carboxyethylsilatriol sodium salt or 2- (carboxymethylthio)ethyltrimethylsilane; PEG-containing silane reagents are 2-[methoxy(polyethyleneoxy)propyl]-trimethoxy-silane, 2-[methoxy(polyethyleneoxy)propyl]heptamethyltrisiloxane or 2-[methoxy(polyethyleneoxy)propyl]-trichlorosilane. The above-mentioned carboxyethylsilanetriol sodium salt is named carboxyethylsilanetriol sodium in English; 2-(carboxymethylthio)ethyltrimethylsilane, whose chemical formula is C7 H16 O2 SSi; 2-[methoxy(polyethyleneoxy)propyl]-trimethoxy-silane, named in Chinese 2-[methoxy(polyethyleneoxy)propyl]trimethoxysilane; 2-[methoxy(polyethyleneoxy)propyl]heptamethyltrisiloxane, Chinese name 2-methyl-3-hydroxypropylmethyl (siloxane and polysiloxane); 2-[methoxy (polyethyleneoxy) propyl]-trichlorosilane, chemical formula CH3 O (C2 H4 O)6-9 C3 H6 Cl3 Si, these reagents are available in the market, manufacturers Optional American Gelest Inc. company.
本发明探针主体是由不同形貌的贵金属纳米颗粒组装而形成的链状结构,链状结构表面包覆溶胶凝胶SiO2层,SiO2层表面修饰羟基(-OH),羧基(-COOH),巯基(-SH),氨基(-NH2),聚乙(烯)二醇(polyethylene glycol,PEG)中的一种, 链状结构所含有的纳米晶包括各种贵金属纳米晶,如Au、Ag、Pt、Pd纯纳米晶以及它们形成的合金及核壳结构纳米晶。纳米晶的自组装由各种化合物协助在溶液中完成,包括极性的有机分子如醇类(甲醇、乙醇、丙醇)、巯基乙酸、巯基丙酸、乙醇胺、二乙醇胺、三乙醇胺;其它极性无机分子,如硼氢化钠;各种硅烷试剂,如正硅酸甲酯、正硅酸乙酯、正硅酸丙酯、正硅酸丁酯。探针的主要组成成分除含有金属纳米晶外,还含有Si、H、S、C、O、Na、N、B 等元素。探针的制备方法包括纳米颗粒的制备、纳米晶在室温下的自组装、组装后溶胶凝胶SiO2包覆以及表面官能团修饰等步骤。探针的直径由纳米颗粒的直径及SiO2层厚度决定,探针的长度由纳米颗粒的自组装过程控制,该类探针具有不同拉曼散射效应,可用于Raman散射检测、传感器及其它生物检测领域,也可以用于催化化学、电导材料等领域。The main body of the probe of the present invention is a chain structure formed by the assembly of precious metal nanoparticles with different shapes. The surface of the chain structure is covered with a sol-gel SiO2 layer, and the surface of the SiO2 layer is modified with hydroxyl (-OH), carboxyl (-COOH) ), mercapto (-SH), amino (-NH2 ), one of polyethylene glycol (polyethylene glycol, PEG), and the nanocrystals contained in the chain structure include various noble metal nanocrystals, such as Au , Ag, Pt, Pd pure nanocrystals and their alloys and core-shell structure nanocrystals. The self-assembly of nanocrystals is assisted in solution by various compounds, including polar organic molecules such as alcohols (methanol, ethanol, propanol), mercaptoacetic acid, mercaptopropionic acid, ethanolamine, diethanolamine, triethanolamine; other polar organic molecules Sexual inorganic molecules, such as sodium borohydride; various silane reagents, such as methyl orthosilicate, ethyl orthosilicate, propyl orthosilicate, and butyl orthosilicate. The main composition of the probe contains not only metal nanocrystals, but also Si, H, S, C, O, Na, N, B and other elements. The preparation method of the probe includes the steps of preparation of nanoparticles, self-assembly of nanocrystals at room temperature, sol-gel SiO2 coating after assembly, and surface functional group modification. The diameter of the probe is determined by the diameter of the nanoparticle and the thickness of theSiO2 layer. The length of the probe is controlled by the self-assembly process of the nanoparticle. This type of probe has different Raman scattering effects and can be used for Raman scattering detection, sensors and other biological In the field of detection, it can also be used in the fields of catalytic chemistry and conductive materials.
附图说明Description of drawings
图1 金纳米颗粒的透射电镜照片;Fig. 1 Transmission electron micrograph of gold nanoparticles;
图2 透射电镜照片,TEOS引起的Au纳米颗粒的自组装;Figure 2 Transmission electron micrographs, self-assembly of Au nanoparticles induced by TEOS;
图3 探针的透射电镜照片;Fig. 3 Transmission electron micrograph of the probe;
图4 金纳米颗粒和探针样品的紫外可见吸收谱。Fig. 4 UV-Vis absorption spectra of gold nanoparticles and probe samples.
具体实施方式Detailed ways
下面通过具体实施例对本发明进行进一步阐述。本发明所用到的水相合成的贵金属纳米颗粒在现有文献中有相关报道,纳米颗粒的合成并不是本发明的创新点,本领域技术人员可根据记载的文献得到本发明所用的贵金属纳米颗粒,下述实施例着重解释本发明技术方案部分,应该明白的是,下述说明仅是示例性的,并不对本发明进行限制。如无特别说明,本发明所制得的贵金属纳米颗粒粒径在1 ~ 25 nm范围内,探针的长度为3 nm ~ 10 μm,探针的直径为3 ~ 40 nm,探针表面的SiO2层厚度为0.5 ~ 20 nm。The present invention will be further elaborated below by specific examples. The noble metal nanoparticles synthesized in the water phase used in the present invention have relevant reports in the existing literature. The synthesis of nanoparticles is not a novelty of the present invention. Those skilled in the art can obtain the noble metal nanoparticles used in the present invention according to the document recorded. , the following examples focus on explaining the technical solutions of the present invention. It should be understood that the following descriptions are only exemplary and do not limit the present invention. Unless otherwise specified, the particle size of the noble metal nanoparticles prepared in the present invention is in the range of 1-25 nm, the length of the probe is 3 nm-10 μm, the diameter of the probe is 3-40 nm, and the SiO on the surface of the probe is The thickness of the2 layers is 0.5 ~ 20 nm.
实施例1Example 1
1.1采用氧化还原法制备Au纳米颗粒(NPs)(详见文献Langmuir 2004, 20, 1909-1904。)1.1 Preparation of Au nanoparticles (NPs) by redox method (see the
首先,在单口烧瓶中加入18.5 mL水,再加入0.5 mL 0.01 M柠檬酸钠溶液,搅拌均匀,置于冰浴中。在搅拌下加入0.5 mL 1 mM的氯金酸,冰水浴中冷却溶液。然后,在强烈搅拌下慢慢地加入0.5 mL 0.1 M硼氢化钠,溶液变为橙色,低速离心下对产物进行提纯,得到的Au NPs的粒径大约为3-4 nm。First, add 18.5 mL of water to a single-necked flask, then add 0.5 mL of 0.01 M sodium citrate solution, stir well, and place in an ice bath. Add 0.5 mL of 1 mM chloroauric acid under stirring, and cool the solution in an ice-water bath. Then, 0.5 mL of 0.1 M sodium borohydride was slowly added under strong stirring, the solution turned orange, and the product was purified by low-speed centrifugation, and the particle size of the obtained Au NPs was about 3-4 nm.
1.2采用正硅酸乙酯对Au NPs进行自组装。强烈搅拌下,在8 mL乙醇和0.1 mL 25%的氨水的混合液中加入1 mL 0.1 μM的Au 溶液,再加入3 μL正硅酸四乙酯,其注入速度为0.05 μL/min,继续反应3 h。反应后的溶液在15000 rpm的速度下离心10 min,上层清液弃去,用乙醇洗涤沉淀物两次,离心分离,最后将沉淀物重新分散在水和乙醇的溶液中,得到Au NPs的一维自组装结构。1.2 Self-assembly of Au NPs using tetraethyl orthosilicate. Under strong stirring, add 1 mL of 0.1 μM Au solution to the mixture of 8 mL of ethanol and 0.1 mL of 25% ammonia water, and then add 3 μL of tetraethylorthosilicate at an injection rate of 0.05 μL/min, and continue the reaction 3 h. The reacted solution was centrifuged at 15,000 rpm for 10 min, the supernatant was discarded, the precipitate was washed twice with ethanol, centrifuged, and finally the precipitate was redispersed in a solution of water and ethanol to obtain a mixture of Au NPs. self-assembled structures.
1.3采用正硅酸乙酯对Au纳米颗粒自组装进行SiO2包覆。将Au 纳米颗粒的一维自组装结构分散到1mL水中,加入6 mL 乙醇和0.1 mL 25%的氨水, 再加入20 uL的正硅酸乙酯,搅拌反应4小时,反应后的溶液在15000 rpm的速度下离心5 min,上层清液弃去,用乙醇洗涤沉淀物两次,离心分离,最后将沉淀物重新分散在水和乙醇的溶液中,得到Au/SiO2复合颗粒。1.3SiO2 coating of Au nanoparticle self-assembly with tetraethyl orthosilicate. Disperse the one-dimensional self-assembled structure of Au nanoparticles into 1 mL of water, add 6 mL of ethanol and 0.1 mL of 25% ammonia water, then add 20 uL of tetraethyl orthosilicate, and stir for 4 hours. Centrifuge at a high speed for 5 min, discard the supernatant, wash the precipitate twice with ethanol, centrifuge, and finally redisperse the precipitate in a solution of water and ethanol to obtain Au/SiO2 composite particles.
1.4取1 mL上述步骤1.3制备的Au/SiO2复合颗粒的溶液,加入氨丙基三甲氧基硅烷1uL,搅拌反应5小时,反应完后,离心分离并用乙醇洗涤,与拉曼分子链接后得到SiO2层包覆的一维Au NPs纳米链拉曼探针。1.4 Take 1 mL of the solution of Au/SiO2 composite particles prepared in the above step 1.3, add 1uL of aminopropyltrimethoxysilane, stir and react for 5 hours, after the reaction, centrifuge and wash with ethanol, and link with Raman molecules to obtain One-dimensional Au NPs nanochain Raman probe coated with SiOlayer .
实施例2Example 2
2.1采用氧化还原法制备Au NPs(详见文献Langmuir 2008, 24, 5562-5568)。取1250 μL 0.01 M 氯金酸用水稀释到总体积为50 mL,加入到三口烧瓶中,加热至沸,快速加入2 mL 1% 柠檬酸钠水溶液,继续煮沸10 min,撤去热源,再搅拌15 min,冷却到室温,低速离心下对产物进行提纯,反应得到的Au NPs的粒径大约为8 nm。2.1 Preparation of Au NPs by redox method (see literature Langmuir 2008, 24, 5562-5568 for details). Take 1250 μL of 0.01 M chloroauric acid diluted with water to a total volume of 50 mL, add it to a three-neck flask, heat to boiling, quickly add 2 mL of 1% sodium citrate aqueous solution, continue to boil for 10 min, remove the heat source, and stir for another 15 min , cooled to room temperature, and the product was purified by low-speed centrifugation. The particle size of the Au NPs obtained from the reaction was about 8 nm.
2.2采用巯基丙酸对Au 纳米颗粒进行自组装(详见文献Langmuir. 2010, 26, 10005-10012)。取1 mL 0.5 μM的Au 纳米颗粒溶液,加入1 mL 乙醇,搅拌均匀,溶液颜色为红色,加入0.5 mL 1 mM的巯基丙酸,搅拌24 h后,溶液颜色变为蓝色,组装后的Au 纳米颗粒为珍珠链状。2.2 Self-assembly of Au nanoparticles using mercaptopropionic acid (see the literature Langmuir. 2010, 26, 10005-10012 for details). Take 1 mL of 0.5 μM Au nanoparticle solution, add 1 mL of ethanol, stir evenly, the color of the solution is red, add 0.5 mL of 1 mM mercaptopropionic acid, stir for 24 h, the color of the solution turns blue, and the assembled Au The nanoparticles are in the shape of pearl chains.
2.3采用正硅酸四甲酯直接对Au NPs进行包覆。在1 mL 0.2 μM的上述组装后的Au 纳米颗粒溶液中加入4 mL乙醇和0.1 mL 25%的氨水,搅拌均匀。在搅拌下加入4 μL正硅酸四甲酯,其注入速度为0.2 μL/min,继续反应3 h。反应后的溶液在15000 rpm的速度下离心10 min,上层清液弃去,用乙醇洗涤沉淀物两次,离心分离,最后将沉淀物重新分散在水和乙醇的溶液中,得到SiO2包覆后Au 纳米颗粒的一维自组装结构。2.3 The Au NPs were directly coated with tetramethyl orthosilicate. Add 4 mL of ethanol and 0.1 mL of 25% ammonia water to 1 mL of 0.2 μM assembled Au nanoparticles solution, and stir well. Add 4 μL tetramethyl orthosilicate with stirring at an injection rate of 0.2 μL/min, and continue the reaction for 3 h. The reacted solution was centrifuged at 15,000 rpm for 10 min, the supernatant was discarded, the precipitate was washed twice with ethanol, centrifuged, and finally the precipitate was redispersed in a solution of water and ethanol to obtaina SiO coating One-dimensional self-assembled structure of post-Au nanoparticles.
2.4取1 mL上述步骤2.3制备的包覆有SiO2层的Au 纳米颗粒的一维自组装结构的溶液,加入氨丙基三甲氧基硅烷1.5uL,搅拌反应6小时,反应完后,离心分离并用乙醇洗涤,与拉曼分子链接后得到含有Au/SiO2复合颗粒显示拉曼增强效应的探针。2.4 Take 1 mL of the one-dimensional self-assembled structure solution of Au nanoparticles coated withSiO2 layer prepared in the above step 2.3, add 1.5uL of aminopropyltrimethoxysilane, stir and react for 6 hours, after the reaction, centrifuge And washed with ethanol, after linking with Raman molecules, a probe containing Au/SiO2 composite particles showing Raman enhancement effect is obtained.
实施例3Example 3
3.1 用经典的合成方法,在强烈搅拌下,于2 mL水中依次加入25 μL 20 mM 氯金酸、25 μL 0.1 M柠檬酸钠、3 mL乙醇和冷冻过的100 μL 0.1 M NaBH4。当加入硼氢化钠后,溶液的颜色由浅黄色变为橙色,继续搅拌10 min,离心分离后得到Au纳米颗粒。3.1 Using the classic synthesis method, add 25 μL of 20 mM chloroauric acid, 25 μL of 0.1 M sodium citrate, 3 mL of ethanol and 100 μL of frozen 0.1 M NaBH4 to 2 mL of water successively under vigorous stirring. When sodium borohydride was added, the color of the solution changed from light yellow to orange, stirring was continued for 10 min, and Au nanoparticles were obtained after centrifugation.
3.2采用极性分子乙醇或丙醇对Au 纳米颗粒进行自组装(详见文献J. Phys. Chem. C. 2007, 111, 17158-17162)。把金纳米颗粒分散于乙醇和水的溶液里,改变溶剂中乙醇和水的用量(ethanol/water= 0/5, 2/3, 1/1, 3/2, and 5/0),可以得到组装后不同形貌的Au NPs。其它试剂不变,将乙醇换为丙醇,也可以对Au 纳米颗粒进行组装。3.2 Self-assembly of Au nanoparticles using polar molecules ethanol or propanol (see J. Phys. Chem. C. 2007, 111, 17158-17162 for details). Disperse the gold nanoparticles in the solution of ethanol and water, change the amount of ethanol and water in the solvent (ethanol/water= 0/5, 2/3, 1/1, 3/2, and 5/0), you can get Au NPs with different morphologies after assembly. Other reagents remain unchanged, and Au nanoparticles can also be assembled by changing ethanol to propanol.
3.3采用正硅酸四丙酯直接对Au 纳米颗粒进行包覆。在1 mL 0.2 μM的上述组装后的Au 纳米颗粒溶液中加入1 mL乙醇和1 mL 25%的氨水,搅拌均匀。在搅拌下加入2 μL正硅酸四丙酯,其注入速度为0.2 μL/min,继续反应3 h。反应后的溶液在15000 rpm的速度下离心10 min,上层清液弃去,用乙醇洗涤沉淀物两次,离心分离,最后将沉淀物重新分散在水和乙醇的溶液中,得到SiO2包覆后Au 纳米颗粒的一维自组装结构。3.3 The Au nanoparticles were directly coated with tetrapropyl orthosilicate. Add 1 mL of ethanol and 1 mL of 25% ammonia water to 1 mL of 0.2 μM assembled Au nanoparticles solution, and stir well. Add 2 μL tetrapropyl orthosilicate with stirring at an injection rate of 0.2 μL/min, and continue the reaction for 3 h. The reacted solution was centrifuged at 15,000 rpm for 10 min, the supernatant was discarded, the precipitate was washed twice with ethanol, centrifuged, and finally the precipitate was redispersed in a solution of water and ethanol to obtaina SiO coating One-dimensional self-assembled structure of post-Au nanoparticles.
3.4取1 mL上述步骤3.2制备的包覆有SiO2层的Au纳米颗粒的一维自组装结构的溶液,加入氨丙基三甲氧基硅烷0.5 uL,搅拌反应4小时,反应完后,离心分离并用乙醇洗涤,之后分散于水中,与拉曼分子链接后得到含有Au/SiO2复合颗粒显示拉曼增强效应的探针。3.4 Take 1 mL of the solution of the one-dimensional self-assembled structure of Au nanoparticles coated withSiO2 layer prepared in the above step 3.2, add 0.5 uL of aminopropyltrimethoxysilane, stir and react for 4 hours, after the reaction, centrifuge and washed with ethanol, then dispersed in water, and linked with Raman molecules to obtain a probe containing Au/SiO2 composite particles showing Raman enhancement effect.
实施例4Example 4
4.1采用氧化还原法制备Au 纳米颗粒(详见文献Langmuir 2008, 24, 5562-5568)。取1250 μL 0.01 M 氯金酸用水稀释到总体积为50 mL,加入到三口烧瓶中,加热至沸,快速加入850 μL 1% 柠檬酸钠水溶液,继续煮沸10 min,撤去热源,再搅拌15 min,冷却到室温,低速离心下对产物进行提纯,反应得到的Au 纳米颗粒的直径大约为25 nm。4.1 Preparation of Au nanoparticles by redox method (see literature Langmuir 2008, 24, 5562-5568 for details). Take 1250 μL of 0.01 M chloroauric acid diluted with water to a total volume of 50 mL, add it to a three-neck flask, heat to boiling, quickly add 850 μL of 1% sodium citrate aqueous solution, continue to boil for 10 minutes, remove the heat source, and stir for another 15 minutes , cooled to room temperature, and the product was purified under low-speed centrifugation, and the diameter of the Au nanoparticles obtained by the reaction was about 25 nm.
4.2采用硼氢化钠对Au 纳米颗粒进行自组装(详见文献Langmuir. 2010, 26, 9214-9223)。取2 mL 0.2 μM的Au 溶液于小瓶中,加入0.1 mL 1 mM冰冻过的硼氢化钠溶液,搅拌24 h后,溶液颜色变为蓝色,组装后的Au纳米颗粒为珍珠链状的。4.2 Self-assembly of Au nanoparticles using sodium borohydride (see the literature Langmuir. 2010, 26, 9214-9223 for details). Take 2 mL of 0.2 μM Au solution in a vial, add 0.1 mL of 1 mM frozen sodium borohydride solution, stir for 24 h, the color of the solution turns blue, and the assembled Au nanoparticles are in the shape of pearl chains.
4.3采用正硅酸四丁酯对组装后的Au 纳米颗粒进行包覆。在1 mL 0.2 μM的上述组装后的Au 纳米颗粒溶液中加入1 mL乙醇和0.2 mL 25%的氨水,搅拌均匀。在搅拌下加入10 μL正硅酸四丁酯,其注入速度为0.2 μL/min,继续反应10 h。反应后的溶液在15000 rpm的速度下离心10 min,上层清液弃去,用乙醇洗涤沉淀物两次,离心分离,最后将沉淀物重新分散在水和乙醇的溶液中,得到SiO2包覆后Au 纳米颗粒的一维自组装结构。4.3 Coating the assembled Au nanoparticles with tetrabutyl orthosilicate. Add 1 mL of ethanol and 0.2 mL of 25% ammonia water to 1 mL of 0.2 μM assembled Au nanoparticles solution, and stir well. Add 10 μL tetrabutyl orthosilicate with stirring at an injection rate of 0.2 μL/min, and continue the reaction for 10 h. The reacted solution was centrifuged at 15,000 rpm for 10 min, the supernatant was discarded, the precipitate was washed twice with ethanol, centrifuged, and finally the precipitate was redispersed in a solution of water and ethanol to obtaina SiO coating One-dimensional self-assembled structure of post-Au nanoparticles.
4.4取1 mL上述步骤4.3制备的包覆有SiO2层的Au 纳米颗粒的一维自组装结构的溶液,加入氨丙基三甲氧基硅烷1uL,搅拌反应4小时,反应完后,离心分离并用乙醇洗涤,之后分散于水中,与拉曼分子链接后得到含有Au/SiO2复合颗粒显示拉曼增强效应的探针。4.4 Take 1 mL of the solution of the one-dimensional self-assembled structure of Au nanoparticles coated withSiO2 layer prepared in the above step 4.3, add 1uL of aminopropyltrimethoxysilane, stir and react for 4 hours, after the reaction, centrifuge and use Washed with ethanol, then dispersed in water, and linked with Raman molecules to obtain probes containing Au/SiO2 composite particles showing Raman enhancement effect.
实施例5Example 5
5.1采用氧化还原法制备Ag 纳米颗粒(详见文献Irit Lubitz and Alexander Kotlyar. Bioconjugate Chemistry,2011年1月11日被收录)。将0.45 mL 0.1 M 新制备的AgNO3溶液加入到180 mL预冷到4℃的水中并置于冰浴中。然后在强烈搅拌下加入0.9 mL 50 mM的柠檬酸钠溶液和0.75 mL 0.6 M的NaBH4溶液。溶液颜色变为亮黄色。将溶液4℃下放置24小时,颜色变为深黄色。室温下,在强烈搅拌下加入0.72 mL 2.5 M氯化锂溶液,继续搅拌15 min。在11000 rpm的离心速度下离心1.2 h。丢弃上层清液,沉淀分散在水中,制备的Ag 纳米颗粒的粒径大约为10 nm。5.1 Preparation of Ag nanoparticles by redox method (for details, see literature Irit Lubitz and Alexander Kotlyar. Bioconjugate Chemistry, included on January 11, 2011). Add 0.45 mL of 0.1 M freshly preparedAgNO solution to 180 mL of water pre-cooled to 4 °C and place in an ice bath. Then add 0.9 mL of 50 mM sodium citrate solution and 0.75 mL of 0.6 MNaBH4 solution under vigorous stirring. The solution color changed to bright yellow. The solution was left at 4°C for 24 hours, and the color changed to dark yellow. At room temperature, 0.72 mL of 2.5 M lithium chloride solution was added under vigorous stirring, and the stirring was continued for 15 min. Centrifuge at 11000 rpm for 1.2 h. The supernatant was discarded, the precipitate was dispersed in water, and the particle size of the prepared Ag nanoparticles was about 10 nm.
5.2采用巯基乙酸对Ag 纳米颗粒进行自组装。取2 mL 0.5 μM的Ag NPs 溶液于小瓶中,加入1 mL 乙醇,搅拌均匀,加入1mL 1 mM的巯基乙酸,搅拌3 h后,得到组装后的Ag 纳米颗粒。5.2 Self-assembly of Ag nanoparticles using thioglycolic acid. Take 2 mL of 0.5 μM Ag NPs solution in a vial, add 1 mL of ethanol, stir evenly, add 1 mL of 1 mM thioglycolic acid, and stir for 3 h to obtain assembled Ag nanoparticles.
5.3采用正硅酸四乙酯对组装后的Ag 纳米颗粒进行包覆。在1 mL 0.2 μM的上述组装后的Ag NPs溶液中加入1 mL乙醇和0.1 mL 25%的氨水,搅拌均匀。在搅拌下加入8 μL正硅酸四乙酯,其注入速度为0.2 μL/min,继续反应5 h。反应后的溶液在15000 rpm的速度下离心10 min,上层清液弃去,用乙醇洗涤沉淀物两次,离心分离,最后将沉淀物重新分散在水和乙醇的溶液中,得到SiO2包覆后Ag NPs的一维自组装结构。5.3 Coating the assembled Ag nanoparticles with tetraethylorthosilicate. Add 1 mL of ethanol and 0.1 mL of 25% ammonia water to 1 mL of 0.2 μM above assembled Ag NPs solution, and stir well. 8 μL tetraethyl orthosilicate was added under stirring at an injection rate of 0.2 μL/min, and the reaction was continued for 5 h. The reacted solution was centrifuged at 15,000 rpm for 10 min, the supernatant was discarded, the precipitate was washed twice with ethanol, centrifuged, and finally the precipitate was redispersed in a solution of water and ethanol to obtaina SiO coating One-dimensional self-assembled structure of Ag NPs.
5.4取1 mL上述步骤5.3制备的包覆有SiO2层的Ag NPs的一维自组装结构的溶液,加入氨丙基三甲氧基硅烷1uL,搅拌反应3.5小时,反应完后,离心分离并用乙醇洗涤,之后分散于水中,与拉曼分子链接后得到含有Ag/SiO2复合颗粒显示拉曼增强效应的探针。5.4 Take 1 mL of the solution of the one-dimensional self-assembled structure of Ag NPs coated withSiO2 layer prepared in the above step 5.3, add 1uL of aminopropyltrimethoxysilane, stir and react for 3.5 hours, after the reaction, centrifuge and wash with ethanol After washing, dispersing in water, and linking with Raman molecules, a probe containing Ag/SiO2 composite particles showing Raman enhancement effect was obtained.
实施例6Example 6
6.1 采用氧化还原法制备Pt纳米颗粒(详见文献Langmuir. 2002, 18, 3318-3318)。在冰浴中,强烈搅拌下将20 mL 0.01 M硼氢化钠溶液逐滴加入到20 mL 0.65 mM六氯铂酸钾中,反应3 h。溶液颜色由黄褐色变为暗灰色,低速离心下对产物进行提纯,制备的Pt 纳米颗粒的粒径大约为7 nm。6.1 Preparation of Pt nanoparticles by redox method (see literature Langmuir. 2002, 18, 3318-3318 for details). In an ice bath, 20 mL of 0.01 M sodium borohydride solution was added dropwise to 20 mL of 0.65 mM potassium hexachloroplatinate under vigorous stirring, and reacted for 3 h. The color of the solution changed from yellowish brown to dark gray, and the product was purified under low-speed centrifugation, and the particle size of the prepared Pt nanoparticles was about 7 nm.
6.2采用乙醇胺对Pt NPs进行自组装。取2 mL 0.1 μM的Pt 纳米颗粒溶液于小瓶中,加入1 mL 乙醇,搅拌均匀,加入1 mL 1mM的乙醇胺,搅拌48 h后,得到组装后的Pt 纳米颗粒。6.2 Self-assembly of Pt NPs using ethanolamine. Take 2 mL of 0.1 μM Pt nanoparticle solution in a vial, add 1 mL of ethanol, stir evenly, add 1 mL of 1 mM ethanolamine, and stir for 48 h to obtain assembled Pt nanoparticles.
6.3采用正硅酸四乙酯对组装后的Pt纳米颗粒进行包覆。在1 mL 0.2 μM的上述组装后的Pt 纳米颗粒溶液中加入2 mL乙醇和0.1 mL 25%的氨水,搅拌均匀。在搅拌下加入3 μL正硅酸四乙酯,其注入速度为0.2 μL/min,继续反应3 h。反应后的溶液在15000 rpm的速度下离心10 min,上层清液弃去,用乙醇洗涤沉淀物两次,离心分离,最后将沉淀物重新分散在水和乙醇的溶液中,得到SiO2包覆后Pt 纳米颗粒的一维自组装结构。6.3 Coating the assembled Pt nanoparticles with tetraethylorthosilicate. Add 2 mL of ethanol and 0.1 mL of 25% ammonia water to 1 mL of 0.2 μM assembled Pt nanoparticles solution, and stir well. Add 3 μL tetraethyl orthosilicate with stirring at an injection rate of 0.2 μL/min, and continue the reaction for 3 h. The reacted solution was centrifuged at 15,000 rpm for 10 min, the supernatant was discarded, the precipitate was washed twice with ethanol, centrifuged, and finally the precipitate was redispersed in a solution of water and ethanol to obtaina SiO coating One-dimensional self-assembled structures of post-Pt nanoparticles.
6.4取1 mL上述步骤6.3制备的包覆有SiO2层的Pt 纳米颗粒的一维自组装结构的溶液,加入氨丙基三甲氧基硅烷2 uL,搅拌反应6小时,反应完后,离心分离并用乙醇洗涤,之后分散于水中,与拉曼分子链接后得到含有Pt/SiO2复合颗粒显示拉曼增强效应的探针。6.4 Take 1 mL of the solution of the one-dimensional self-assembled structure of Pt nanoparticles coated withSiO2 layer prepared in the above step 6.3, add 2 uL of aminopropyltrimethoxysilane, stir and react for 6 hours, after the reaction, centrifuge and washed with ethanol, then dispersed in water, and linked with Raman molecules to obtain a probe containing Pt/SiO2 composite particles showing Raman enhancement effect.
实施例7Example 7
7.1采用氧化还原法制备Ag/Au 核壳纳米晶(详见文献J. Phys. Chem. C. 2007, 111, 5909-5914)。磁力搅拌下,在50 mL 0.4 mM 的AgNO3水溶液中加入5 mL 1 % 柠檬酸钠溶液,将溶液加热到95 ℃,保持15 min。然后逐滴加入0.8 mL 25 mM氯金酸,继续加热15 min。将溶液冷却到室温。反应后的溶液经过多次离心分离和洗涤,洗去未反应的物质,将制备的Ag/Au 核壳纳米晶重新分散在水中,得到粒径大约为13 nm的Ag/Au 核壳纳米晶。7.1 Preparation of Ag/Au core-shell nanocrystals by redox method (see J. Phys. Chem. C. 2007, 111, 5909-5914 for details). Under magnetic stirring, 5 mL of 1% sodium citrate solution was added to 50 mL of 0.4 mM AgNO3 aqueous solution, and the solution was heated to 95 °C for 15 min. Then 0.8 mL of 25 mM chloroauric acid was added dropwise, and heating was continued for 15 min. The solution was cooled to room temperature. The reacted solution was centrifuged and washed several times to remove unreacted substances, and the prepared Ag/Au core-shell nanocrystals were redispersed in water to obtain Ag/Au core-shell nanocrystals with a particle size of about 13 nm.
7.2采用正硅酸四甲酯直接对Ag/Au 核壳纳米晶进行自组装。强烈搅拌下,在4 mL乙醇和0.1 mL 25%的氨水中加入1 mL 0.2 μM的上Ag/Au 核壳纳米晶溶液,再加入2 μL正硅酸四甲酯,其注入速度为0.2 μL/min,反应6 h。 反应后的溶液在15000 rpm的速度下离心10 min,上层清液弃去,用乙醇洗涤沉淀物两次,离心分离,最后将沉淀物重新分散在水和乙醇的溶液中,得到Ag/Au 核壳纳米晶的一维自组装结构。7.2 Direct self-assembly of Ag/Au core-shell nanocrystals using tetramethylorthosilicate. Under vigorous stirring, add 1 mL of 0.2 μM upper Ag/Au core-shell nanocrystal solution to 4 mL of ethanol and 0.1 mL of 25% ammonia water, and then add 2 μL of tetramethyl orthosilicate at an injection rate of 0.2 μL/ min, the reaction time is 6 h. The reacted solution was centrifuged at 15,000 rpm for 10 min, the supernatant was discarded, the precipitate was washed twice with ethanol, centrifuged, and finally the precipitate was redispersed in a solution of water and ethanol to obtain the Ag/Au core One-dimensional self-assembled structures of shell nanocrystals.
7.3采用正硅酸四甲酯直接对Ag/Au 核壳纳米晶自组装进行SiO2包覆,强烈搅拌下,在4 mL乙醇和0.2 mL 25%的氨水中加入1 mL 0.2 μM的上述组装后的Ag/Au 核壳纳米晶溶液,再加入12 μL正硅酸四甲酯,继续反应6 h。 反应后的溶液在15000 rpm的速度下离心10 min,上层清液弃去,用乙醇洗涤沉淀物两次,离心分离,最后将沉淀物重新分散在水和乙醇的溶液中,得到Ag/Au/SiO2复合颗粒。7.3 Use tetramethyl orthosilicate to directly coat the self-assembly of Ag/Au core-shell nanocrystals with SiO2 , and add 1 mL of 0.2 μM in 4 mL of ethanol and 0.2 mL of 25% ammonia water under strong stirring. 12 μL tetramethyl orthosilicate was added to the Ag/Au core-shell nanocrystal solution, and the reaction was continued for 6 h. The reacted solution was centrifuged at 15,000 rpm for 10 min, the supernatant was discarded, the precipitate was washed twice with ethanol, centrifuged, and finally the precipitate was redispersed in a solution of water and ethanol to obtain Ag/Au/ SiO2 composite particles.
7.4取1 mL上述步骤7.3制备的Ag/Au/SiO2复合颗粒的溶液,加入氨丙基三甲氧基硅烷1uL,搅拌反应4小时,反应完后,离心分离并用乙醇洗涤,得到氨基修饰的、Ag/Au/SiO2复合颗粒,与拉曼分子链接后得到含有Ag/Au/SiO2复合颗粒显示拉曼增强效应的探针。7.4 Take 1 mL of the Ag/Au/SiO2 composite particle solution prepared in the above step 7.3, add 1uL of aminopropyltrimethoxysilane, stir and react for 4 hours, after the reaction, centrifuge and wash with ethanol to obtain amino-modified, The Ag/Au/SiO2 composite particles are linked with Raman molecules to obtain a probe containing Ag/Au/SiO2 composite particles showing Raman enhancement effect.
实施例8Example 8
8.1采用氧化还原法制备Au NPs(详见文献Langmuir 2008, 24, 5562-5568)。取1250 μL 0.01 M氯金酸用水稀释到总体积为50 mL,加入到三口烧瓶中,加热至沸,快速加入1300 μL 1% 柠檬酸钠水溶液,继续煮沸10 min,撤去热源,再搅拌15 min,冷却到室温,低速离心下对产物进行提纯,反应得到的Au 纳米颗粒的粒径大约为15 nm。8.1 Preparation of Au NPs by redox method (see Langmuir 2008, 24, 5562-5568 for details). Take 1250 μL of 0.01 M chloroauric acid diluted with water to a total volume of 50 mL, add it into a three-neck flask, heat to boiling, quickly add 1300 μL of 1% sodium citrate aqueous solution, continue to boil for 10 minutes, remove the heat source, and stir for another 15 minutes , cooled to room temperature, and the product was purified under low-speed centrifugation, and the particle size of the Au nanoparticles obtained by the reaction was about 15 nm.
8.2采用二乙醇胺对Au纳米颗粒进行自组装。取1 mL 0.5 μM的Au 溶液于小瓶中,加入1 mL 乙醇,搅拌均匀,加入1 mL 1 mM的二乙醇胺,搅拌24 h后,溶液颜色变为紫红色,组装后的Au纳米颗粒多为二聚体。8.2 Self-assembly of Au nanoparticles using diethanolamine. Take 1 mL of 0.5 μM Au solution in a vial, add 1 mL of ethanol, stir evenly, add 1 mL of 1 mM diethanolamine, and stir for 24 h, the solution color turns purple, and the assembled Au nanoparticles are mostly two Polymer.
8.3采用正硅酸四丙酯对组装后的Au纳米颗粒进行包覆。强烈搅拌下,在4 mL乙醇和0.1 mL 25%的氨水中加入1 mL 0.2 μM的上述组装后的Au NPs 溶液,再加入1 μL正硅酸四丙酯,其注入速度为0.2 μL/min,继续反应12 h。反应后的溶液在15000 rpm的速度下离心10 min,上层清液弃去,用乙醇洗涤沉淀物两次,离心分离,最后将沉淀物重新分散在水中,得到Au/SiO2复合颗粒。8.3 Coating the assembled Au nanoparticles with tetrapropyl orthosilicate. Under strong stirring, add 1 mL of 0.2 μM above assembled Au NPs solution to 4 mL of ethanol and 0.1 mL of 25% ammonia water, and then add 1 μL of tetrapropyl orthosilicate at an injection rate of 0.2 μL/min, Continue to react for 12 h. The reacted solution was centrifuged at 15,000 rpm for 10 min, the supernatant was discarded, the precipitate was washed twice with ethanol, centrifuged, and finally the precipitate was redispersed in water to obtain Au/SiO2 composite particles.
8.4取1 mL上述步骤8.3制备的Au/SiO2复合颗粒的溶液,加入巯丙基三甲氧基硅烷1uL,搅拌反应10小时,反应完后,离心分离并用乙醇洗涤,得到巯基修饰的、Au/SiO2复合颗粒,与拉曼分子链接后得到含有Au/SiO2复合颗粒显示拉曼增强效应的探针。8.4 Take 1 mL of the solution of Au/SiO2 composite particles prepared in the above step 8.3, add 1 uL of mercaptopropyltrimethoxysilane, stir and react for 10 hours, after the reaction, centrifuge and wash with ethanol to obtain mercapto-modified, Au/SiO2 Composite particles are linked with Raman molecules to obtain probes containing Au/SiO2 composite particles showing Raman enhancement effect.
实施例9Example 9
9.1采用氧化还原法制备Au 纳米颗粒(详见文献Langmuir 2008, 24, 5562-5568。)9.1 Preparation of Au nanoparticles by redox method (see Langmuir 2008, 24, 5562-5568 for details.)
取1250 μL 0.01 M 氯金酸用水稀释到总体积为50 mL,加入到三口烧瓶中,加热至沸,快速加入1000 μL 1% 柠檬酸钠水溶液,继续煮沸10 min,撤去热源,再搅拌15 min,冷却到室温,低速离心下对产物进行提纯,反应得到的Au 纳米颗粒的直径大约为18 nm。Take 1250 μL of 0.01 M chloroauric acid diluted with water to a total volume of 50 mL, add it into a three-neck flask, heat to boiling, quickly add 1000 μL of 1% sodium citrate aqueous solution, continue to boil for 10 minutes, remove the heat source, and stir for another 15 minutes , cooled to room temperature, and the product was purified under low-speed centrifugation, and the diameter of the Au nanoparticles obtained by the reaction was about 18 nm.
9.2采用三乙醇胺对Au 纳米颗粒进行自组装。取1 mL 0.5 μM的Au 溶液于小瓶中,加入1 mL 乙醇,搅拌均匀,加入1 mL 1 mM的三乙醇胺,搅拌5 h后,溶液颜色变为蓝紫色,组装后的Au NPs多为珍珠链状结构。9.2 Self-assembly of Au nanoparticles using triethanolamine. Take 1 mL of 0.5 μM Au solution in a vial, add 1 mL of ethanol, stir evenly, add 1 mL of 1 mM triethanolamine, and stir for 5 h, the color of the solution turns blue-purple, and the assembled Au NPs are mostly pearl chains shape structure.
9.3采用正硅酸四丁酯对组装后的Au纳米颗粒进行包覆。强烈搅拌下,在4 mL乙醇和0.1 mL 25%的氨水中加入1 mL 0.2 μM的组装后的Au 纳米颗粒溶液,再加入1 μL正硅酸四丁酯,其注入速度为0.2 μL/min,继续反应48 h。反应后的溶液在15000 rpm的速度下离心10 min,上层清液弃去,用乙醇洗涤沉淀物两次,离心分离,最后将沉淀物重新分散在水中,得到Au/SiO2复合颗粒。9.3 Coating the assembled Au nanoparticles with tetrabutyl orthosilicate. Under strong stirring, add 1 mL of 0.2 μM assembled Au nanoparticle solution to 4 mL of ethanol and 0.1 mL of 25% ammonia water, and then add 1 μL of tetrabutyl orthosilicate at an injection rate of 0.2 μL/min. Continue to react for 48 h. The reacted solution was centrifuged at 15,000 rpm for 10 min, the supernatant was discarded, the precipitate was washed twice with ethanol, centrifuged, and finally the precipitate was redispersed in water to obtain Au/SiO2 composite particles.
9.4取1 mL上述步骤9.3制备的Au/SiO2复合颗粒的溶液,加入2-[methoxy(polyethyleneoxy)propyl]-trimethoxy-silane 2 uL,搅拌反应6小时,反应完后,离心分离并用乙醇洗涤,得到PEG基修饰的、Au/SiO2复合颗粒,与拉曼分子链接后得到含有Au/SiO2复合颗粒显示拉曼增强效应的探针。9.4 Take 1 mL of the Au/SiO2 composite particle solution prepared in the above step 9.3, add 2-[methoxy(polyethyleneoxy)propyl]-trimethoxy-silane 2 uL, stir and react for 6 hours, after the reaction, centrifuge and wash with ethanol, PEG-based modified Au/SiO2 composite particles were obtained, and after linking with Raman molecules, a probe containing Au/SiO2 composite particles showing Raman enhancement effect was obtained.
实施例10Example 10
10.1采用氧化还原法制备Au 纳米颗粒。称取90 mg柠檬酸钠置于100 mL三口烧瓶中,加入100 mL水,磁力搅拌,加热至沸。在沸腾下于3 min内均匀加入1 mL 50 mM氯金酸水溶液,之后再煮沸4 min。取下,流水冷却到室温。用3000-MWCO的超滤管在6000 rpm离心速度下对产物进行洗涤,浓缩,将未反应的反应物洗去,反应得到的Au纳米颗粒的粒径大约为11 nm。10.1 Preparation of Au nanoparticles by redox method. Weigh 90 mg of sodium citrate and place it in a 100 mL three-neck flask, add 100 mL of water, stir magnetically, and heat to boiling. Add 1 mL of 50 mM chloroauric acid aqueous solution evenly within 3 min under boiling, and then boil for 4 min. Remove, and cool to room temperature under running water. The product was washed with a 3000-MWCO ultrafiltration tube at a centrifugal speed of 6000 rpm, concentrated, and unreacted reactants were washed away, and the particle size of the Au nanoparticles obtained by the reaction was about 11 nm.
10.2采用乙二胺对Au 纳米颗粒进行自组装。取1 mL 0.5 μM的Au 溶液于小瓶中,加入1 mL 乙醇,搅拌均匀,加入0.1 mL 1 mM的乙二胺,搅拌5 h后,溶液颜色变为蓝紫色,组装后的Au 纳米颗粒多为珍珠链状结构。10.2 Self-assembly of Au nanoparticles using ethylenediamine. Take 1 mL of 0.5 μM Au solution in a vial, add 1 mL of ethanol, stir evenly, add 0.1 mL of 1 mM ethylenediamine, and stir for 5 h, the color of the solution turns blue-purple, and the assembled Au nanoparticles are mostly Pearl chain structure.
10.3采用正硅酸四乙酯对组装后的Au 纳米颗粒进行包覆。强烈搅拌下,在4 mL乙醇和0.1 mL 25%的氨水中加入1 mL 0.2 μM的Au 溶液,再加入5 μL正硅酸四乙酯,其注入速度为0.2 μL/min,继续反应48 h。反应后的溶液在15000 rpm的速度下离心10 min,上层清液弃去,用乙醇洗涤沉淀物两次,离心分离,最后将沉淀物重新分散在水中,得到Au/SiO2复合颗粒。10.3 Coat the assembled Au nanoparticles with tetraethylorthosilicate. Under vigorous stirring, 1 mL of 0.2 μM Au solution was added to 4 mL of ethanol and 0.1 mL of 25% ammonia water, and then 5 μL of tetraethylorthosilicate was added at an injection rate of 0.2 μL/min, and the reaction was continued for 48 h. The reacted solution was centrifuged at 15,000 rpm for 10 min, the supernatant was discarded, the precipitate was washed twice with ethanol, centrifuged, and finally the precipitate was redispersed in water to obtain Au/SiO2 composite particles.
10.4取1 mL上述步骤10.3制备的Au/SiO2复合颗粒的溶液,加入巯丙基三甲氧基硅烷1uL,搅拌反应10小时,反应完后,离心分离并用乙醇洗涤,得到巯基修饰的、Au/SiO2复合颗粒,与拉曼分子链接后得到含有Au/SiO2复合颗粒显示拉曼增强效应的探针。10.4
实施例11Example 11
11.1 Au NPs的制备方法同上实施例10.1。11.1 The preparation method of Au NPs is the same as in Example 10.1 above.
11.2采用正硅酸四甲酯直接对Au纳米晶进行自组装。强烈搅拌下,在4 mL乙醇和0.1 mL 25%的氨水中加入1 mL 0.2 μM的上Au纳米晶溶液,再加入2 μL正硅酸四甲酯,其注入速度为0.2 μL/min,反应6 h。 反应后的溶液在15000 rpm的速度下离心10 min,上层清液弃去,用乙醇洗涤沉淀物两次,离心分离,最后将沉淀物重新分散在水和乙醇的溶液中,得到Au纳米晶的一维自组装结构。11.2 Direct self-assembly of Au nanocrystals using tetramethylorthosilicate. Under vigorous stirring, add 1 mL of 0.2 μM Au nanocrystal solution to 4 mL of ethanol and 0.1 mL of 25% ammonia water, and then add 2 μL of tetramethyl orthosilicate at an injection rate of 0.2 μL/min. React 6 h. The reacted solution was centrifuged at 15,000 rpm for 10 min, the supernatant was discarded, the precipitate was washed twice with ethanol, centrifuged, and finally the precipitate was redispersed in a solution of water and ethanol to obtain Au nanocrystals. One-dimensional self-assembled structures.
11.3采用正硅酸四甲酯对Au纳米晶自组装进行SiO2包覆。强烈搅拌下,在4 mL乙醇和0.2 mL 25%的氨水中加入1 mL 0.2 μM的上述组装后的Au纳米颗粒溶液,再加入12 μL正硅酸四甲酯,继续反应6 h。 反应后的溶液在15000 rpm的速度下离心10 min,上层清液弃去,用乙醇洗涤沉淀物两次,离心分离,最后将沉淀物重新分散在水和乙醇的溶液中,得到Au/SiO2复合颗粒。11.3SiO coating of Au nanocrystal self-assembly using tetramethylorthosilicate. Under vigorous stirring, 1 mL of 0.2 μM Au nanoparticle solution assembled above was added to 4 mL of ethanol and 0.2 mL of 25% ammonia water, and then 12 μL of tetramethylorthosilicate was added, and the reaction was continued for 6 h. The reacted solution was centrifuged at 15,000 rpm for 10 min, the supernatant was discarded, the precipitate was washed twice with ethanol, centrifuged, and finally the precipitate was redispersed in a solution of water and ethanol to obtain Au/SiO2 Composite particles.
11.4取1 mL上述步骤11.3制备的Au/SiO2复合颗粒的溶液,加入2-(carboxymethylthio)ethyltrimethylsilane硅烷1uL,搅拌反应4小时,反应完后,离心分离并用乙醇洗涤,得到氨基修饰的、Au/SiO2复合颗粒,与拉曼分子链接后得到含有Au/SiO2复合颗粒显示拉曼增强效应的探针。11.4
实施例12Example 12
12.1 Ag 纳米颗粒的制备方法同上实施例5.1。12.1 The preparation method of Ag nanoparticles is the same as in Example 5.1 above.
12.2采用正硅酸四丙酯对Ag纳米晶进行自组装。强烈搅拌下,在4 mL乙醇和0.1 mL 25%的氨水中加入1 mL 0.2 μM的上Ag纳米晶溶液,再加入2 μL正硅酸四丙酯,其注入速度为0.2 μL/min,反应6 h。 反应后的溶液在15000 rpm的速度下离心10 min,上层清液弃去,用乙醇洗涤沉淀物两次,离心分离,最后将沉淀物重新分散在水和乙醇的溶液中,得到Ag纳米晶的一维自组装结构。12.2 Self-assembly of Ag nanocrystals using tetrapropyl orthosilicate. Under strong stirring, add 1 mL of 0.2 μM Ag nanocrystal solution to 4 mL of ethanol and 0.1 mL of 25% ammonia water, and then add 2 μL of tetrapropyl orthosilicate at an injection rate of 0.2 μL/min. h. The reacted solution was centrifuged at a speed of 15000 rpm for 10 min, the supernatant was discarded, the precipitate was washed twice with ethanol, centrifuged, and finally the precipitate was redispersed in a solution of water and ethanol to obtain Ag nanocrystals. One-dimensional self-assembled structures.
12.3采用正硅酸四丁酯直接对Ag纳米晶自组装进行SiO2包覆 强烈搅拌下,在4 mL乙醇和0.2 mL 25%的氨水中加入1 mL 0.2 μM的上述组装后的Ag纳米晶溶液,再加入12 μL正硅酸四丁酯,继续反应6 h。 反应后的溶液在15000 rpm的速度下离心10 min,上层清液弃去,用乙醇洗涤沉淀物两次,离心分离,最后将沉淀物重新分散在水和乙醇的溶液中,得到Ag /SiO2复合颗粒。12.3 Using tetrabutyl orthosilicate to directly self-assemble Ag nanocrystals for SiO2 coating. Under vigorous stirring, add 1 mL of 0.2 μM solution of the above-assembled Ag nanocrystals to 4 mL of ethanol and 0.2 mL of 25% ammonia water , and then added 12 μL tetrabutyl orthosilicate, and continued the reaction for 6 h. The reacted solution was centrifuged at 15,000 rpm for 10 min, the supernatant was discarded, the precipitate was washed twice with ethanol, centrifuged, and finally the precipitate was redispersed in a solution of water and ethanol to obtain Ag/SiO2 Composite particles.
12.4取1 mL上述步骤12.3制备的Ag/SiO2复合颗粒的溶液,加入氨丙基三甲氧基硅烷1uL,搅拌反应4小时,反应完后,离心分离并用乙醇洗涤,得到氨基修饰的、Ag/ SiO2复合颗粒,与拉曼分子链接后得到含有Ag /SiO2复合颗粒显示拉曼增强效应的探针。12.4
实施例13Example 13
13.1 Pt NPs的制备方法同上实施例6.1。13.1 The preparation method of Pt NPs is the same as in Example 6.1 above.
13.2采用正硅酸四乙酯对Pt纳米晶进行自组装。强烈搅拌下,在4 mL乙醇和0.1 mL 25%的氨水中加入1 mL 0.2 μM的上Pt纳米晶溶液,再加入2 μL正硅酸四乙酯,其注入速度为0.2 μL/min,反应6 h。 反应后的溶液在15000 rpm的速度下离心10 min,上层清液弃去,用乙醇洗涤沉淀物两次,离心分离,最后将沉淀物重新分散在水和乙醇的溶液中,得到Pt纳米晶的一维自组装结构。13.2 Self-assembly of Pt nanocrystals using tetraethylorthosilicate. Under vigorous stirring, add 1 mL of 0.2 μM Pt nanocrystal solution to 4 mL of ethanol and 0.1 mL of 25% ammonia water, and then add 2 μL of tetraethyl orthosilicate at an injection rate of 0.2 μL/min. React 6 h. The reacted solution was centrifuged at a speed of 15,000 rpm for 10 min, the supernatant was discarded, the precipitate was washed twice with ethanol, centrifuged, and finally the precipitate was redispersed in a solution of water and ethanol to obtain Pt nanocrystals. One-dimensional self-assembled structures.
13.3采用正硅酸四丁酯直接对Pt纳米晶自组装进行SiO2包覆 强烈搅拌下,在4 mL甲醇和0.2 mL 25%的氨水中加入1 mL 0.2 μM的上述组装后的Pt纳米晶溶液,再加入12 μL正硅酸四丁酯,继续反应6 h。 反应后的溶液在15000 rpm的速度下离心10 min,上层清液弃去,用乙醇洗涤沉淀物两次,离心分离,最后将沉淀物重新分散在水和乙醇的溶液中,得到Pt/SiO2复合颗粒。13.3 Using tetrabutyl orthosilicate to directly self-assemble Pt nanocrystals for SiO2 coating Add 1 mL of 0.2 μM solution of the above-assembled Pt nanocrystals to 4 mL of methanol and 0.2 mL of 25% ammonia under vigorous stirring , and then added 12 μL tetrabutyl orthosilicate, and continued the reaction for 6 h. The reacted solution was centrifuged at 15,000 rpm for 10 min, the supernatant was discarded, the precipitate was washed twice with ethanol, centrifuged, and finally the precipitate was redispersed in a solution of water and ethanol to obtain Pt/SiO2 Composite particles.
13.4取1 mL上述步骤13.3制备的Pt/SiO2复合颗粒的溶液,加入氨丙基三甲氧基硅烷1uL,搅拌反应4小时,反应完后,离心分离并用乙醇洗涤,得到氨基修饰的、Pt/SiO2复合颗粒,与拉曼分子链接后得到含有Pt/SiO2复合颗粒显示拉曼增强效应的探针。13.4
实施例14Example 14
14.1采用氧化还原法制备Pd NPs14.1 Preparation of Pd NPs by redox method
在三口瓶中加入5 mL 2 mM H2PdCl4溶液,磁力搅拌下加入0.5 mL1 %柠檬酸钠溶液,搅拌均匀后,加入200 μL H2O2,反应完毕后,低速离心下对产物进行提纯,制得Pd NPs。Add 5 mL of 2 mM H2 PdCl4 solution into the three-neck flask, add 0.5 mL of 1% sodium citrate solution under magnetic stirring, after stirring evenly, add 200 μL of H2 O2 , after the reaction is complete, purify the product under low-speed centrifugation , to prepare Pd NPs.
14.2采用正硅酸四甲酯直接对Pd纳米晶进行自组装。强烈搅拌下,在4 mL乙醇和0.1 mL 25%的氨水中加入1 mL 0.2 μM的上Pd纳米晶溶液,再加入3 μL正硅酸四甲酯,其注入速度为0.3 μL/min,反应8 h。 反应后的溶液在15000 rpm的速度下离心10 min,上层清液弃去,用乙醇洗涤沉淀物两次,离心分离,最后将沉淀物重新分散在水和乙醇的溶液中,得到Pd纳米晶的一维自组装结构。14.2 Direct self-assembly of Pd nanocrystals using tetramethylorthosilicate. Under strong stirring, add 1 mL of 0.2 μM Pd nanocrystal solution to 4 mL of ethanol and 0.1 mL of 25% ammonia water, and then add 3 μL of tetramethyl orthosilicate at an injection rate of 0.3 μL/min, react 8 h. The reacted solution was centrifuged at a speed of 15000 rpm for 10 min, the supernatant was discarded, the precipitate was washed twice with ethanol, centrifuged, and finally the precipitate was redispersed in a solution of water and ethanol to obtain Pd nanocrystals. One-dimensional self-assembled structures.
14.3采用正硅酸四甲酯直接对Pd纳米晶自组装进行SiO2包覆 强烈搅拌下,在5 mL乙醇和0.2 mL 25%的氨水中加入1 mL 0.2 μM的上述组装后的Pd纳米晶溶液,再加入12 uL正硅酸四甲酯,继续反应5 h。反应后的溶液在15000 rpm的速度下离心10 min,上层清液弃去,用乙醇洗涤沉淀物两次,离心分离,最后将沉淀物重新分散在水和乙醇的溶液中,得到Pt/SiO2复合颗粒。14.3 Use tetramethylorthosilicate to directly self-assemble Pd nanocrystals for SiO2 coating. Under vigorous stirring, add 1 mL of 0.2 μM solution of the above-assembled Pd nanocrystals to 5 mL of ethanol and 0.2 mL of 25% ammonia water , and then added 12 uL tetramethyl orthosilicate, and continued the reaction for 5 h. The reacted solution was centrifuged at 15,000 rpm for 10 min, the supernatant was discarded, the precipitate was washed twice with ethanol, centrifuged, and finally the precipitate was redispersed in a solution of water and ethanol to obtain Pt/SiO2 Composite particles.
14.4取1 mL上述步骤14.3制备的Pt/SiO2复合颗粒的溶液,加入氨丙基三甲氧基硅烷1uL,搅拌反应5小时,反应完后,离心分离并用乙醇洗涤,得到氨基修饰的、Pt/SiO2复合颗粒,与拉曼分子链接后得到含有Pt/SiO2复合颗粒显示拉曼增强效应的探针。14.4
实施例15Example 15
15.1采用氧化还原法制备Ag/Au 合金纳米晶(详见文献J. Phys. Chem. C. 2007, 111, 5909-5914)。磁力搅拌下,在50 mL 0.4 mM 的AgNO3水溶液中和0.5 mL 25 mM氯金酸加入5 mL 1 % 柠檬酸钠溶液,将溶液加热到95 ℃,保持15 min。将溶液冷却到室温。反应后的溶液经过多次离心分离和洗涤,洗去未反应的物质,将制备的Ag/Au 合金纳米晶重新分散在水中,得到粒径大约为13 nm的Ag/Au 合金纳米晶。15.1 Preparation of Ag/Au alloy nanocrystals by redox method (see J. Phys. Chem. C. 2007, 111, 5909-5914 for details). Under magnetic stirring, 5 mL of 1% sodium citrate solution was added to 50 mL of 0.4 mM AgNO3 aqueous solution and 0.5 mL of 25 mM chloroauric acid, and the solution was heated to 95 °C for 15 min. The solution was cooled to room temperature. The reacted solution was centrifuged and washed several times to remove unreacted substances, and the prepared Ag/Au alloy nanocrystals were redispersed in water to obtain Ag/Au alloy nanocrystals with a particle size of about 13 nm.
15.2采用正硅酸四甲酯直接对Ag/Au 合金纳米晶进行自组装。强烈搅拌下,在4 mL乙醇和0.1 mL 25%的氨水中加入1 mL 0.2 μM的上Ag/Au 合金纳米晶溶液,再加入2 μL正硅酸四甲酯,其注入速度为0.2 μL/min,反应6 h。 反应后的溶液在15000 rpm的速度下离心10 min,上层清液弃去,用乙醇洗涤沉淀物两次,离心分离,最后将沉淀物重新分散在水和乙醇的溶液中,得到Ag/Au 合金纳米晶的一维自组装结构。15.2 Direct self-assembly of Ag/Au alloy nanocrystals using tetramethylorthosilicate. Under strong stirring, add 1 mL of 0.2 μM Ag/Au alloy nanocrystal solution to 4 mL of ethanol and 0.1 mL of 25% ammonia water, and then add 2 μL of tetramethyl orthosilicate at a rate of 0.2 μL/min , reacted for 6 h. The reacted solution was centrifuged at 15,000 rpm for 10 min, the supernatant was discarded, the precipitate was washed twice with ethanol, centrifuged, and finally the precipitate was redispersed in a solution of water and ethanol to obtain an Ag/Au alloy One-dimensional self-assembled structures of nanocrystals.
15.3采用正硅酸四甲酯直接对Ag/Au 合金纳米晶自组装进行SiO2包覆 强烈搅拌下,在4 mL乙醇和0.2 mL 25%的氨水中加入1 mL 0.2 μM的上述组装后的Ag/Au 合金纳米晶溶液,再加入12 μL正硅酸四甲酯,继续反应6 h。 反应后的溶液在15000 rpm的速度下离心10 min,上层清液弃去,用乙醇洗涤沉淀物两次,离心分离,最后将沉淀物重新分散在水和乙醇的溶液中,得到Ag/Au合金/SiO2复合颗粒。15.3 Use tetramethylorthosilicate to directly self-assemble Ag/Au alloy nanocrystals for SiO2 coating. Under strong stirring, add 1 mL of 0.2 μM Ag after assembly in 4 mL of ethanol and 0.2 mL of 25% ammonia water /Au alloy nanocrystal solution, and then add 12 μL tetramethyl orthosilicate, and continue to react for 6 h. The reacted solution was centrifuged at 15,000 rpm for 10 min, the supernatant was discarded, the precipitate was washed twice with ethanol, centrifuged, and finally the precipitate was redispersed in a solution of water and ethanol to obtain an Ag/Au alloy /SiO2 composite particles.
15.4取1 mL上述步骤15.3制备的Ag/Au合金/SiO2复合颗粒的溶液,加入氨丙基三甲氧基硅烷1uL,搅拌反应4小时,反应完后,离心分离并用乙醇洗涤,得到氨基修饰的、Ag/Au合金/SiO2复合颗粒,与拉曼分子链接后得到含有Ag/Au合金/SiO2复合颗粒显示拉曼增强效应的探针。15.4
| Application Number | Priority Date | Filing Date | Title |
|---|---|---|---|
| CN201210023975.7ACN102608097B (en) | 2012-02-03 | 2012-02-03 | Probe with adjustable Raman scattering effect, and preparation method thereof |
| Application Number | Priority Date | Filing Date | Title |
|---|---|---|---|
| CN201210023975.7ACN102608097B (en) | 2012-02-03 | 2012-02-03 | Probe with adjustable Raman scattering effect, and preparation method thereof |
| Publication Number | Publication Date |
|---|---|
| CN102608097Atrue CN102608097A (en) | 2012-07-25 |
| CN102608097B CN102608097B (en) | 2014-04-02 |
| Application Number | Title | Priority Date | Filing Date |
|---|---|---|---|
| CN201210023975.7AExpired - Fee RelatedCN102608097B (en) | 2012-02-03 | 2012-02-03 | Probe with adjustable Raman scattering effect, and preparation method thereof |
| Country | Link |
|---|---|
| CN (1) | CN102608097B (en) |
| Publication number | Priority date | Publication date | Assignee | Title |
|---|---|---|---|---|
| CN103523747A (en)* | 2013-10-10 | 2014-01-22 | 天津工业大学 | Self-assembly preparation of one-dimensional nuclear shell nano-structure |
| CN103521778A (en)* | 2013-10-10 | 2014-01-22 | 天津工业大学 | Self-assembly preparation of one-dimensional nano-structure |
| CN103990812A (en)* | 2014-06-06 | 2014-08-20 | 厦门大学 | Method for preparing surface enhanced Raman substrate |
| CN104122248A (en)* | 2014-07-03 | 2014-10-29 | 上海师范大学 | A kind of Raman probe of Fe3+ with surface-enhanced Raman effect and its preparation method and application |
| CN104607654A (en)* | 2015-02-10 | 2015-05-13 | 济南大学 | Self-assembly material based on silver nanoparticles and preparation method thereof |
| CN104792765A (en)* | 2015-03-20 | 2015-07-22 | 江苏师范大学 | Silver nanoparticle, SERS active substrate, preparation method and application of SERS active substrate |
| CN104874789A (en)* | 2015-05-12 | 2015-09-02 | 济南大学 | A Controllable Preparation Method of Ultrathin Shell Au@SiO2 Nanocomposite |
| CN104998592A (en)* | 2015-07-09 | 2015-10-28 | 北京航空航天大学 | Multilayer core-shell structure Au@SiO2@Ag@SiO2 nanocomposite material and its preparation method |
| CN110031446A (en)* | 2019-04-28 | 2019-07-19 | 河南大学 | The method for detecting photic nanoparticles in polymers spatial distribution using Raman image technology |
| CN110146482A (en)* | 2019-05-13 | 2019-08-20 | 上海大学 | A Novel Near Field Raman Scattering Detection Device |
| CN111659899A (en)* | 2020-04-21 | 2020-09-15 | 华南师范大学 | Flower-like palladium oxide-gold nano composite material and preparation method and application thereof |
| CN114309588A (en)* | 2021-12-16 | 2022-04-12 | 杭州电子科技大学 | A kind of gold nanorod surface modification method |
| CN114309591A (en)* | 2021-12-30 | 2022-04-12 | 杭州电子科技大学 | Self-assembly method for coating thin silicon dioxide gold nanorods |
| CN114381257A (en)* | 2022-01-21 | 2022-04-22 | 吉林大学 | A near-infrared luminescent gold nanocluster ratio fluorescent probe based on thiolactic acid protection and its application in silver ion detection |
| CN114486843A (en)* | 2021-12-17 | 2022-05-13 | 厦门大学 | Difunctional Au @ Pd @ Pt core-shell nanoparticle and preparation method and application thereof |
| CN116148410A (en)* | 2022-12-23 | 2023-05-23 | 苏州大学 | A kind of SERS base material that can be used for continuous TLC detection and its preparation method and application |
| CN116297382A (en)* | 2022-09-07 | 2023-06-23 | 深圳达闼科技控股有限公司 | Nanoparticle and application thereof in preparation of detection kit for surface-enhanced Raman scattering |
| CN117250345A (en)* | 2023-11-20 | 2023-12-19 | 重庆医科大学绍兴柯桥医学检验技术研究中心 | In-situ detection method of biomolecules in organ chip |
| Publication number | Priority date | Publication date | Assignee | Title |
|---|---|---|---|---|
| US6514767B1 (en)* | 1999-10-06 | 2003-02-04 | Surromed, Inc. | Surface enhanced spectroscopy-active composite nanoparticles |
| CN101230208A (en)* | 2008-01-07 | 2008-07-30 | 首都师范大学 | A method for preparing gold nanorod particles coated with a silicon dioxide layer on the surface |
| EP2040075A1 (en)* | 2007-09-24 | 2009-03-25 | Julius-Maximilians-Universität Würzburg | Compounds and markers for surface-enhanced raman scattering |
| CN101676711A (en)* | 2008-09-21 | 2010-03-24 | 西北师范大学 | Substrate with surface-enhanced Raman scattering activity and preparation method thereof |
| Publication number | Priority date | Publication date | Assignee | Title |
|---|---|---|---|---|
| US6514767B1 (en)* | 1999-10-06 | 2003-02-04 | Surromed, Inc. | Surface enhanced spectroscopy-active composite nanoparticles |
| EP2040075A1 (en)* | 2007-09-24 | 2009-03-25 | Julius-Maximilians-Universität Würzburg | Compounds and markers for surface-enhanced raman scattering |
| CN101230208A (en)* | 2008-01-07 | 2008-07-30 | 首都师范大学 | A method for preparing gold nanorod particles coated with a silicon dioxide layer on the surface |
| CN101676711A (en)* | 2008-09-21 | 2010-03-24 | 西北师范大学 | Substrate with surface-enhanced Raman scattering activity and preparation method thereof |
| Title |
|---|
| WEI WANG ETAL: "Ag@SiO2 Core-Shell Nanoparticles for Probing Spatial Distribution of Electromagnetic Field Enhancement via Surface-Enhanced Raman Scattering", 《ACS NANO 2009》* |
| 祁有丽: "Au及其核壳结构Au@SiO2纳米颗粒的制备、表面修饰及其组装", 《万方学位论文数据库》* |
| 范晓敏 等: "Au@SiO2核壳纳米粒子的制备及其表面增强拉曼光谱", 《高等学校化学学报》* |
| Publication number | Priority date | Publication date | Assignee | Title |
|---|---|---|---|---|
| CN103523747A (en)* | 2013-10-10 | 2014-01-22 | 天津工业大学 | Self-assembly preparation of one-dimensional nuclear shell nano-structure |
| CN103521778A (en)* | 2013-10-10 | 2014-01-22 | 天津工业大学 | Self-assembly preparation of one-dimensional nano-structure |
| CN103990812A (en)* | 2014-06-06 | 2014-08-20 | 厦门大学 | Method for preparing surface enhanced Raman substrate |
| CN104122248A (en)* | 2014-07-03 | 2014-10-29 | 上海师范大学 | A kind of Raman probe of Fe3+ with surface-enhanced Raman effect and its preparation method and application |
| CN104607654A (en)* | 2015-02-10 | 2015-05-13 | 济南大学 | Self-assembly material based on silver nanoparticles and preparation method thereof |
| CN104607654B (en)* | 2015-02-10 | 2016-06-22 | 济南大学 | A kind of self-assembled material based on silver nano-grain and preparation method thereof |
| CN104792765A (en)* | 2015-03-20 | 2015-07-22 | 江苏师范大学 | Silver nanoparticle, SERS active substrate, preparation method and application of SERS active substrate |
| CN104874789A (en)* | 2015-05-12 | 2015-09-02 | 济南大学 | A Controllable Preparation Method of Ultrathin Shell Au@SiO2 Nanocomposite |
| CN104874789B (en)* | 2015-05-12 | 2017-06-23 | 济南大学 | A kind of ultra-thin shell Au@SiO2The controllable method for preparing of nano composite material |
| CN104998592A (en)* | 2015-07-09 | 2015-10-28 | 北京航空航天大学 | Multilayer core-shell structure Au@SiO2@Ag@SiO2 nanocomposite material and its preparation method |
| CN104998592B (en)* | 2015-07-09 | 2017-03-01 | 北京航空航天大学 | Multilayer core-shell structure Au@SiO2@Ag@SiO2 nanocomposite material and its preparation method |
| CN110031446A (en)* | 2019-04-28 | 2019-07-19 | 河南大学 | The method for detecting photic nanoparticles in polymers spatial distribution using Raman image technology |
| CN110146482A (en)* | 2019-05-13 | 2019-08-20 | 上海大学 | A Novel Near Field Raman Scattering Detection Device |
| CN111659899A (en)* | 2020-04-21 | 2020-09-15 | 华南师范大学 | Flower-like palladium oxide-gold nano composite material and preparation method and application thereof |
| CN114309588A (en)* | 2021-12-16 | 2022-04-12 | 杭州电子科技大学 | A kind of gold nanorod surface modification method |
| CN114486843A (en)* | 2021-12-17 | 2022-05-13 | 厦门大学 | Difunctional Au @ Pd @ Pt core-shell nanoparticle and preparation method and application thereof |
| CN114486843B (en)* | 2021-12-17 | 2023-12-19 | 厦门大学 | A bifunctional Au@Pd@Pt core-shell nanoparticle and its preparation method and application |
| CN114309591A (en)* | 2021-12-30 | 2022-04-12 | 杭州电子科技大学 | Self-assembly method for coating thin silicon dioxide gold nanorods |
| CN114309591B (en)* | 2021-12-30 | 2024-11-22 | 杭州电子科技大学 | A method for self-assembly of thin silica-coated gold nanorods |
| CN114381257A (en)* | 2022-01-21 | 2022-04-22 | 吉林大学 | A near-infrared luminescent gold nanocluster ratio fluorescent probe based on thiolactic acid protection and its application in silver ion detection |
| CN114381257B (en)* | 2022-01-21 | 2024-05-07 | 吉林大学 | Near-infrared luminous gold nanocluster ratio type fluorescent probe based on thiolactic acid protection and application of fluorescent probe in silver ion detection |
| CN116297382A (en)* | 2022-09-07 | 2023-06-23 | 深圳达闼科技控股有限公司 | Nanoparticle and application thereof in preparation of detection kit for surface-enhanced Raman scattering |
| CN116148410A (en)* | 2022-12-23 | 2023-05-23 | 苏州大学 | A kind of SERS base material that can be used for continuous TLC detection and its preparation method and application |
| CN117250345A (en)* | 2023-11-20 | 2023-12-19 | 重庆医科大学绍兴柯桥医学检验技术研究中心 | In-situ detection method of biomolecules in organ chip |
| CN117250345B (en)* | 2023-11-20 | 2024-02-13 | 重庆医科大学绍兴柯桥医学检验技术研究中心 | In-situ detection method of biomolecules in organ chip |
| Publication number | Publication date |
|---|---|
| CN102608097B (en) | 2014-04-02 |
| Publication | Publication Date | Title |
|---|---|---|
| CN102608097B (en) | Probe with adjustable Raman scattering effect, and preparation method thereof | |
| Li et al. | Shape-dependent surface-enhanced Raman scattering in gold–Raman-probe–silica sandwiched nanoparticles for biocompatible applications | |
| Croissant et al. | Organosilica hybrid nanomaterials with a high organic content: syntheses and applications of silsesquioxanes | |
| McVey et al. | Solution synthesis, optical properties, and bioimaging applications of silicon nanocrystals | |
| CN111289493B (en) | A kind of surface-enhanced Raman substrate and preparation method thereof | |
| Buining et al. | Preparation of functional silane-stabilized gold colloids in the (sub) nanometer size range | |
| CN103990812B (en) | A kind of preparation method of surface enhanced Raman substrate | |
| CN101111338B (en) | Metal microparticles, method for producing the same, composition containing the same, and use thereof | |
| CN103286312A (en) | Surface-common-enhanced fluorescence surface-enhanced Raman multi-layer core-shell structure composite particles and preparation method of particles | |
| Bonacchi et al. | Luminescent chemosensors based on silica nanoparticles | |
| Duan et al. | Surface enhanced Raman scattering by graphene-nanosheet-gapped plasmonic nanoparticle arrays for multiplexed DNA detection | |
| CN102382640B (en) | Quantum dot composite particle with high fluorescence brightness, immunological detection probe and preparation method of composite particle | |
| CN102590176A (en) | Surface-enhanced Raman scattering probe and preparation method thereof | |
| CN105149612A (en) | A method for coating Au@Ag core-shell nanorods with SiO2 | |
| EP3227037B1 (en) | Universal one-pot and up-scalable synthesis of sers encoded nanoparticles | |
| CN102925158A (en) | Multi-shell-structure quantum dot composite particle, and high-fluorescent-brightness quantum dot probe and preparation method thereof | |
| CN109762557B (en) | Inorganic fluorescent nano particle and preparation method and application thereof | |
| CN102756125B (en) | Method for fabricating nanohybrids, the nanohybrids | |
| Mannelli et al. | Recent advances in analytical and bioanalysis applications of noble metal nanorods | |
| CN104998592B (en) | Multilayer core-shell structure Au@SiO2@Ag@SiO2 nanocomposite material and its preparation method | |
| CN101003729A (en) | Nano incandescnet particles of composite organic dyestuff of silicon dioxide with dual structures, and preparation method | |
| JP2010535938A (en) | Coated colloidal material | |
| CN105798289A (en) | Preparation method and application of carbon shell isolated noble metal nanoparticles | |
| CN101851502B (en) | Ag@SiO2 fluorescent nanoparticles doped with ruthenium terpyridyl and its preparation method | |
| CN111944152A (en) | Preparation and application of a CdTe/CdSe@MIPs QDs molecularly imprinted polymer |
| Date | Code | Title | Description |
|---|---|---|---|
| C06 | Publication | ||
| PB01 | Publication | ||
| C10 | Entry into substantive examination | ||
| SE01 | Entry into force of request for substantive examination | ||
| C14 | Grant of patent or utility model | ||
| GR01 | Patent grant | ||
| CF01 | Termination of patent right due to non-payment of annual fee | ||
| CF01 | Termination of patent right due to non-payment of annual fee | Granted publication date:20140402 Termination date:20200203 |